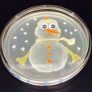

Are We Making Progress on the Antibiotic Resistance Front?
Antibiotic resistance is a problem that crosses sectors, industries, species, and frankly, requires a widespread effort to make a dent in the problem. Whether it be stewardship among medical providers, surveillance and rapid isolation, or use within agriculture, this is a global issue that we’re just not doing that well in. While the latest CDC report shows that annual deaths due to drug-resistant infections is decreasing since their last analysis, the number of infections occurring is still quite high. In 2013 it was reported that 2.6 million infections occur annually and in this latest report, they found that each year there are 2.8 million antibiotic-resistant infections resulting in 35,000 deaths. Moreover, the 2019 report shows 5 new urgent threats and 2 new threats, which emphasizes the role of stewardship initiatives and One Health. “But there is plenty to worry about. Though hospitals are making headway, the agency found some of the greatest increases in infections are acquired outside hospitals. Also, the threat of antibiotic resistance is remarkably fluid; new threats arise even as old ones are mitigated. For example, the CDC has raised the alert level to ‘urgent” for Candida auris, a multi-drug-resistant yeast that can cause invasive infection and death’.” At a global level, the World Health Organization (WHO) has worked to guide national action plans, which countries can employ and modify to their specified needs. Hint: we’ll be doing a spotlight on resistant fungal infections within this newsletter so make sure to keep reading.
The Mystery and the Truth Surrounding the Explosion at Vektor
Since the explosion in September, there’s been growing conversation around what really happened at Vektor, but also the immediate media coverage that was often over-hyped and opportunistic. Dr. Filippa Lentzos has broken down the facts and ultimately, the implications of those rapid reports. Citing inspections from the WHO-led team, she notes that previously, the site had met international biosecurity and biosafety standards as a smallpox repository. While Vektor’s history includes being an offensive weapons site during the era prior to the Biological Weapons Convention (BCW) and some time after, it has been transformed to a site for research and biodefense. Truly, the biggest issue, Lentzos notes, is the biosafety issues that frequent such research. “Jens Kuhn, a German virologist who was part of a Pentagon-sponsored program that sent young scientists to work in former bioweapons labs, was the first Western scientist through the door at VECTOR in July 2001. Getting in was anything but easy, but once inside he found that contrary to fears he had heard expressed in the West, the high-containment units operated both safely and securely. ‘The Russians don’t want to kill themselves any more than Western scientists,’ Kuhn is quoted as saying in a Nature news story.” While the facility has been upgraded and repaired in recent decades, the Russian government declares biodefense activities and confidence-building measures through the BWC regularly. Sure, they’re doing research with deadly disease like Ebola and Marburg, not to mention storing smallpox, but it’s important to remember that not only is Russia following the International Health Regulations (IHR), which would require them to report risky public health events, but they also did communicate the explosion (although, mostly through the media) and that it happened in the decontamination room – an incident that did not warrant such IHR reporting. As Lentzos underscores, some of the reactions to the event were overblown but this is a prime example of why transparency during such events is critical to avoid misinformation and opportunistic reporting.
Synopsis of the Crimson Contagion 2019 Functional Exercise After-Action Review
This week, the National Biodefense Science Board convened a meeting focusing on the after-action review of the Crimson Contagion 2019 Functional Exercise, a national level exercise series conducted to detect gaps in mechanisms, capabilities, plans, policies, and procedures in the event of a pandemic influenza. Current strategies include the Biological Incident Annex to the Response and Recovery Federal Interagency Operational Plans (2018), Pandemic Influenza Plan (2017 Update), Pandemic Crisis Action Plan Version 2.0, and CDC’s Pandemic Influenza Appendix to the Biological Incident Annex of the CDC All-Hazard Plan (December 2017). These plans, updated over the last few years, were tested by the functional exercise with emphasis on the examination of strategic priorities set by the NSC. Specifically, examined priorities include operational coordination and communications, stabilization and restoration of critical lifelines, national security emergencies, public health emergencies, and continuity. The Crimson Contagion 2019 Functional Exercise included participation of almost 300 entities – 19 federal departments and agencies, 12 states, 15 tribal nations and pueblos, 74 local health departments and coalition regions, 87 hospitals, 40 private sector organizations, and 35 active operations centers. The scenario was a large-scale outbreak of H7N9 avian influenza, originating in China but swiftly spreading to the contiguous US with the first case detected in Chicago, Illinois. Continuous human-to-human transmission of the H7N9 virus encourages its spread across the country and, unfortunately, the stockpiles of H7N9 vaccines are not a match for the outbreak’s strain; however, those vaccines are serviceable as a priming dose. Also, the strain of virus is susceptible to Relenza and Tamiflu antiviral medications. The exercise was intended to deal with a virus outbreak that starts overseas and migrates to the US with scant allocated resources for outbreak response and management, thereby forcing the Department of Health and Human Services (HHS) to include other agencies in the response. To do so, the exercise began 47 days after the identification of the first US case of H7N9 in Chicago, otherwise known as STARTEX conditions. Then, the HHS declared the outbreak as a Public Health Emergency (PHE), the World Health Organization (WHO) declared a pandemic, and the President of the United States declared a National Emergency under the National Emergencies Act. As was the case in the 1918 Great Influenza, transmissibility is high and cases are severe. At STARTEX, there are 2.1 million illnesses and 100 million forecasted illnesses as well as over half a million forecasted deaths. As the pandemic progresses along the epidemiological curve, the overarching foci of the federal-level response adjusts across four phases:
- Operational coordination with public messaging and risk communication
- Situational awareness, information sharing, and reporting
- Financing
- Continuity of operations
The outcome of the Crimson Contagion is that vaccine development is the silver bullet to such an outbreak, but there are complications beyond its formulation. Namely, the minimization of outbreak impact prior to vaccine development and dispersal, strategy for efficient dissemination of the vaccine across the country, allocation of personal protective equipment (PPE), and high expense of vaccine development and PPE acquisitions. The exercise concluded that HHS requires about $10 billion in additional funding immediately following the identification of a novel strain of pandemic influenza. The low inventory levels of PPE and other countermeasures are a result of insufficient domestic manufacturing in the US and a lack of raw materials maintained within US borders. Additionally, the exercise revealed six key findings:
- Existing statutory authorities, policies, and funding of HHS are insufficient for a federal response to an influenza pandemic
- Current planning fails to outline the organizational structure of the federal government response when HHS is the designated lead agency; planning also varies across local, state, territorial, tribal, and federal entities
- There is a lack of clarity in operational coordination regarding the roles and responsibility of agencies as well as in the coordination of information, guidance, and actions of federal agencies, state agencies, and the health sector
- Situation assessment is inefficient and incomplete due to the lack of clear guidance on the information required and confusion in the distribution of recommended protocols and products
- The medical countermeasures supply chain and production capacity are currently insufficient to meet the needs of the country in the event of pandemic influenza
- There is clear dissemination of public health and responder information from the CDC, but confusion about school closures remains
A final report with greater detail of the after-action review of the Crimson Contagion 2019 Functional Exercise is forthcoming. Stay tuned.
Biosecurity Insight
The latest Biosecurity Insight is out, which is a great source for information from the Centre for Biosecurity and Biopreparedness (CBB) established by the Danish Parliament. In this new volume, you can read about the control of CRISPR, fake news and biological weapons (“Pathogens are impossible to see and their effects difficult to understand. This makes the fear of them a dangerous device to be exploited through fake news. In a world where more than half of the population is online, social media can become a device to spread panic and mistrust, and hamper responses to natural disease outbreaks.”), and how the internet enables bioterrorism. You can read more here.
The Nuclear Balancing Act – Energy and Security
On November 14th, the GMU Schar School of Policy and Government hosted a panel conversation on the intersection of nuclear energy and security. “Students and faculty members from the Schar School of Policy and Government, as well as representatives from government agencies and nongovernmental organizations, joined Brent Park, Deputy Administrator for Defense Nuclear Nonproliferation at the U.S. Department of Energy’s National Nuclear Security Administration, and Mikhail Chudakov, Deputy Director General for Nuclear Energy at the International Atomic Energy Agency (IAEA)” to have frank conversations about the future state of nuclear energy and how to address “energy poverty”. Moderated by GMU biodefense professor and graduate program director Dr. Gregory Koblentz, the group discussed the marriage between these two nuclear components and that we ultimately need to continue having these conversations. As Dr. Koblentz noted, “Given the growing demand for carbon-free energy and the dynamic geopolitical situation, it was very informative to hear about how the IAEA and the United States work together to promote safe and secure nuclear energy.”
Biological Weapons Convention Meeting of States Parties (MSP)
This week the MSP began, bringing together states parties engaged in the prohibition of biological weapons. You can read Richard Guthrie’s daily summaries of the meetings here or even watch the livestream on UN Web TV. Hot topics will likely include funding and the current financial state, national implementation, verification, etc. The United Nations Institute for Disarmament Research (UNIDIR) has provided a 30-page overview of compliance and enforcement in the BWC, which you can access here. Written by Filippa Lentzos “this paper takes stock of the mechanisms that are currently available for attempting to determine and ensure compliance with the Biological Weapons Convention (BWC). It presents three conceptual layers of BWC compliance: one legally binding, one politically binding, and one wholly voluntary. The paper also describes a fourth, elusive layer—the verification layer—which remains one of the fundamental challenges of biological disarmament and non-proliferation.” On day 5 of the MSP, Guthrie noted that during the science and technology meeting of experts “there was broad agreement of a need for some form of review arrangement, but with very little detail in the discussion. In the past, for example, some delegations have favoured a small committee of experts while others have favoured some form of arrangement that would allow all states parties to contribute to it. The lack of expressions of support for specific models may be a positive sign as many delegates would seem to prefer achieving consensus on some form of review mechanism rather than pressing for their ideal.”
Missing Links – Understanding Sex- and Gender-Related Impacts of Chemical and Biological Weapons
A new report released via UNIDIR is also addressing the interest that “has grown in gender as a useful analytical perspective to examine the impact of particular means and methods of warfare. Multilateral debates on chemical and biological weapons, however, have not systematically considered the relevance of sex- and age-disaggregated data on the effects of these weapons, nor knowledge of gender dynamics, in the implementation of the Biological and Chemical Weapons Conventions (BWC and CWC, respectively).” Written by Renata Hessmann Dalaqua, James Revill, Alastair Hay, and Nancy D. Connell, this is an extremely detailed and thorough look into the sex and gender dynamics that we often fail to address when it comes to CBW. The report is broken down into several sections – like sex and gender specific effects of chemical and biological weapons, which delves into the social roles and exposure as women are often the primary caregivers, as well as the social stigma and discrimination associated with exposure. Perhaps one of the most interesting sections was on health-seeking behaviors, noting that in some areas, the potential for stigma often impacts if medical care is sought. “Evidence from South Asia, Africa, and Vietnam suggests that the potential for stigmatization affects women’s help-seeking more than men”. Overall, this report was extremely informative and helpful in understanding those roadblocks for not only accurate reporting, but also building the most effective response in the event of an attack.
Using Genome Sequencing to Combat Healthcare Outbreaks
GMU Biodefense doctoral alum Saskia Popescu discusses how genome sequencing can change response to outbreaks in healthcare settings. Infection prevention epidemiologists work hard to identify spikes in usual case counts or rapidly respond to single cases of unusual organisms. Unfortunately, identifying a source or transmission mechanism isn’t always that easy and we often don’t find the proverbial “smoking gun”. However, a study assessed the use of genome sequencing in real-time as a tool to help give hospital epidemiologists and infection control an advantage against microorganisms. Investigators across several universities discussed how they employed the rapid and cost-efficient tool during an outbreak of Acinetobacter baumannii at the Queen Elizabeth Hospital Birmingham in 2011. The source of the outbreak was found to be a military patient from Afghanistan who was being treated for a blast injury. This specific case is unique in that the outbreak lasted an incredibly long time—80 weeks, which is the longest ever studied for Acinetobacter baumannii.
Antimicrobial Resistant Fungal Infections
Fungi are eukaryotic organisms like molds, yeasts, and mushrooms that can be pathogenic in humans. Antifungal medications treat dangerous fungal infections, but antifungal resistant microbes are on the rise, just like antibiotic resistant bacteria. For example, antifungal resistance is increasingly common in severe Candida (a yeast) infections, which often causes nosocomial bloodstream infections. The Centers for Disease Control and Prevention (CDC) released a report on antibiotic resistance threats in the US, which includes a warning about drug-resistant fungi as a serious public health issue. According to the report, 18 microorganisms cause three million antibiotic resistant infections and 35,000 deaths each year. This is the first CDC report to include antibiotic-resistant fungi to include Candida auris along with other resistant Candida species and azole-resistant Aspergillus fumigatus, a mold. Resistance is inherent to certain fungi but can also develop through the misuse and overuse of antifungal and antibiotic drugs in human medicine and agriculture. As with antimicrobial resistance at large, the ubiquitous use of stronger and stronger antimicrobial medications is contributing to the spread of resistance while struggling to combat ongoing infections. The CDC is taking several steps and actions to prevent and reduce resistance:
- Tracking trends in antifungal resistance through the Emerging Infections Program (EIP)
- Supporting a network of regional public health laboratories through the Antibiotic Resistance Laboratory Network (ARLN) to perform antifungal susceptibility testing for Candida
- Using genetic sequencing and developing new laboratory tests to identify and study specific mutations associated with antifungal resistance in Candida
- Summarizing antifungal prescribing patterns across different healthcare facilities to promote appropriate use of antifungals
The CDC’s warning also includes suggestions about what can be done to curb the threat of antifungal resistance:
- Healthcare facility executives and infection control staff can:
- Assess antifungal use as part of their antibiotic stewardship programs
- Ensure adherence to guidelines for hand hygiene, prevention of catheter-associated infections, and environmental infection control
- Doctors and other hospital staff can:
- Prescribe antifungal medications appropriately
- Test for antifungal resistance for patients with invasive disease who are not improving with first-line antifungal medications
- Stay aware of resistance patterns, including antifungal resistance, in your facility and community
- Document the dose, duration, and indication for every antifungal prescription
- Participate in and lead efforts within your hospital to improve antifungal prescribing practices
- Follow hand hygiene and other infection prevention and control guidelines with every patient
Outbreak Dashboard
More attacks have plagued Ebola outbreak response efforts in the DRC, as case counts reach 3,313. Flu activity is also continuing to grow, as B/Victoria viruses are the most common and the CDC reported 8% of respiratory specimens tested by clinical labs were positive for influenza. The CDC is continuing to advise people not to consume romaine lettuce from the Salinas, CA, growing region due to an E. coli O157:H7 outbreak.
News of the Weird
A controversial fence, African swine fever, and Danish critics. In the realm of ASF outbreak response, some are calling the latest efforts in Denmark a waste of money. “On Monday, Denmark completed the fence along the border with Germany to protect its nearly 5,000 pig farms that export 28 million pigs annually, according to the Danish Agriculture and Food Council in a DW.com article. The 1.5-meter tall and half-meter deep fence runs from the Wadden Sea in the west to the Flensburg Fjord in the east. The fence construction cost Denmark around $12 million.” From potentially disrupting migration and an impact on the ecosystem, critics are saying the real threat is the importation of contaminated swine.
Stories You May Have Missed:
- Interview with Ambassador Bonnie Jenkins on Combatting WMD Terrorism – “This interview on 80,000 Hours focuses on Ambassador Bonnie Jenkins’ time as Ambassador at the U.S. Department of State under the Obama administration, where she worked for eight years as Coordinator for Threat Reduction Programs in the Bureau of International Security and Nonproliferation.”
GMU Global Health Security Ambassador

Gene Drives and Frank Discussions With CRISPR Scientists

Chemical Weapons & ISIS
Pandemics, Bioterrorism, & Global Health Security Workshop Instructor Spotlight
Our instructor spotlight this week will shine on FBI Supervisory Special Agent Edward You. Mr. You is like the action hero of the biological countermeasures world (ok, that might be a tad of an exaggeration, but wait until you read about all the amazing things he does with the FBI!). Mr. You is responsible for creating programs and activities to coordinate and improve FBI and interagency efforts to identify, assess, and respond to biological threats or incidents. These efforts include expanding FBI outreach to the Life Sciences community to address biosecurity. Before being promoted to the Weapons of Mass Destruction Directorate, Mr. You was a member of the FBI Los Angeles Field Office Joint Terrorism Task Force and served on the FBI Hazardous Evidence Response Team. Mr. You has also been directly involved in policy-making efforts with a focus on biosecurity. He is an active Working Group member of the National Security Council Interagency Policy Committee on Countering Biological Threats and an Ex Officio member of the NIH National Science Advisory Board for Biosecurity. He also serves on two committees for the National Academies of Sciences, the Institute of Medicine’s Forum on Microbial Threats and the Committee on Science, Technology, and Law’s Forum on Synthetic Biology. Prior to joining the FBI, Mr. You worked for six years in graduate research focusing on retrovirology and human gene therapy at the University of Southern California, Keck School of Medicine. He subsequently worked for three years at the biotechnology firm AMGEN Inc. in cancer research. Special Agent You works to keep the communication channels open between the synthetic biology community and law enforcement to help identify threats and strengthen relations with the biohacker community. Don’t miss the opportunity to learn from Mr. You and pick his brain during our 
Congrats GMU Biodefense Graduates
Payton, Dana Saft, Colleen Tangney, and Anupama Varma. Earning their PhD in biodefense, we’re celebrating Keith W. Ludwick (Dissertation title: The Legend of the Lone Wolf: Categorizing Singular and Small Group Terrorism), Nereyda Sevilla (
Ebola in the DRC – Updates
Double-edged Sword Research